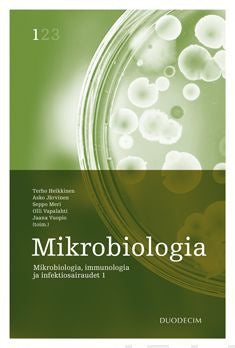

Mikrobiologia
Mikrobiologia-kirjan 4. uudistettu painos on ajantasaistettu Suomen oloihin sopivaksi oppi- ja käsikirjaksi. Mikrobiologisen diagnostiikan viimeaikainen kehitys ja uusien menetelmien käyttöönotto kliinisessä toiminnassa tekevät kirjasta entistäkin ajankohtaisemman. Myös kirjan luettavuuteen on pa... Lue lisää
Mikrobiologia-kirjan 4. uudistettu painos on ajantasaistettu Suomen oloihin sopivaksi oppi- ja käsikirjaksi. Mikrobiologisen diagnostiikan viimeaikainen kehitys ja uusien menetelmien käyttöönotto kliinisessä toiminnassa tekevät kirjasta entistäkin ajankohtaisemman. Myös kirjan luettavuuteen on pa... Lue lisää
-
Tuotekuvaus
Mikrobiologia-kirjan 4. uudistettu painos on ajantasaistettu Suomen oloihin sopivaksi oppi- ja käsikirjaksi. Mikrobiologisen diagnostiikan viimeaikainen kehitys ja uusien menetelmien käyttöönotto kliinisessä toiminnassa tekevät kirjasta entistäkin ajankohtaisemman. Myös kirjan luettavuuteen on panostettu ja kuvat on piirretty uudestaan.
Mikrobiologia käsittelee kattavasti eri bakteereita ja niiden aiheuttamia tauteja. Kirja tutustuttaa lukijansa bakteerien rakenteeseen, toimintaan, genetiikkaan ja luokitteluun. Kirja käsittelee perusteellisesti sieniä ja parasiitteja tauteineen. Lukija perehdytetään myös laajasti viruksiin, niiden yleisiin ominaisuuksiin, rakenteeseen ja virusten aiheuttamiin tauteihin. Huomion saavat mikrobien patogeneesi, virusten osuus syöpätautien syntyyn, geenihoito sekä molekyylivirologian muut sovellukset. Myös prioneista ja prionitaudeista on oma lukunsa.
Mikrobiologia on ensimmäinen osa kolmiosaisesta teoksesta Mikrobiologia, immunologia ja infektiosairaudet. -
Tuotetiedot
- Kustantaja / Valmistaja Duodecim
- ISBN 9789516565487
- Tuotekoodi 9789516565487
- Alanimike Mikrobiologia, immunologia ja infektiosairaudet: kirja 1
- Toimittanut Terho Heikkinen; Asko Järvinen; Seppo Meri; Olli Vapalahti; Jaana Vuopio
- Kieli Suomi
- Thema-luokitus Lääketieteellinen mikrobiologia ja virologia
- Ilmestymispäivä 21.12.2020
- Vuosi 2020
- Painos 4 (4. uud. p)
- Tuoteryhmä Terveys, kasvatus
- Tuotepääryhmä Tietokirjat
- Tuotelinja Kirjat
- Sivumäärä 800
- Avainsanat virukset; sienet; tartuntataudit; virustaudit; mikrobiologia; immunologia; bakteerit; mikrobit; sienitaudit; infektiot; bakteeritaudit; taudinaiheuttajat; loiset; loistaudit; prionit; mikrobiologia mikrobit bakteerit sienet alkueläimet virukset infektiot
- Kirjastoluokka 59.13
- Pituus (mm) 257
- Leveys (mm) 179
- Korkeus (mm) 37
- Paino (g) 1512
- Tuotemuoto Kovakantinen
- Tuoteturvallisuusyhteystiedot Kustannus Oy Duodecim, PL 874 (Kaivokatu 10 A), 00101 HELSINKI
- ALV 13,5%
-
Tuotenäytteet
Tämä tuote kuuluu tuoteryhmiin
Tuotearvostelut Suomalainen.comissa
Tutustu tuotearvostelujen käytäntöihin ja ehtoihin ennen kuin jätät arvostelun.
Suomalainen.com -verkkokaupassa on mahdollista jättää tuotearvosteluja siellä myynnissä olevista tuotteista. Tuotearvosteluja voivat jättää sekä tuotetta Suomalaisesta Kirjakaupasta ostaneet asiakkaat että muut sivuston käyttäjät. Arvostelijan nimimerkin jälkeinen teksti kertoo, onko kyseessä vahvistettu ostaja vai muu asiakas/sivuston käyttäjä.
-
Vahvistettu ostaja - Kyseinen arvostelu on jätetty käyttämällä tuotteen ostajalle lähetettyä sähköpostilinkkiä. Kyseessä on siis vahvistettu ostaja eli arvostelun jättänyt henkilö on ostanut todennetusti kyseisen tuotteen.
-
Vahvistettu suosittelija - Kyseinen arvostelu on jätetty suomalainen.com -verkkosivustolla. Arvostelijan sähköpostiosoite on vahvistettu, jotta on voitu varmistua siitä, että arvostelun on jättänyt oikea henkilö. Suomalainen.com ei kuitenkaan ole vahvistanut, että kyseinen henkilö on ostanut tuotteen.
- Ei tekstiä nimimerkin jälkeen - Kyseinen arvostelu on jätetty suomalainen.com -verkkosivustolla, mutta arvostelun jättäjän sähköpostiosoitetta ei ole vahvistettu.
Tuotearvostelussa pakollisia tietoja ovat tuotteen pistemäärä (tähdet), otsikko sekä arvosteluteksti. Jos jätät arvostelun sinulle lähetetyn sähköpostilinkin kautta, arvostelu julkaistaan käyttämällä etunimeäsi sekä sukunimen ensimmäistä kirjainta.
Jos jätät arvostelun sivustollamme, voit käyttää arvostelussa myös nimimerkkiä. Arvostelun jättämisen yhteydessä sinulta kysytään sähköpostiosoitetta, jonka avulla vahvistamme, että arvostelun on lähettänyt oikea henkilö, eikä esimerkiksi robotti. Tuotearvostelujen palveluntarjoajana toimii Yotpo. Katso Yotpon tietosuojaseloste.
Arvostelut julkaistaan tuotteen kohdalla automaattisesti ja ne tulevat esiin viiveellä. Suomalainen.com pidättää kuitenkin oikeuden poistaa kommentit, jotka sisältävät epäasiallista, herjaavaa tai halventavaa kieltä, vihapuhetta tai ovat muuten hyvän tavan vastaisia, tai joissa markkinoidaan muiden toimijoiden sivustoja tai tuotteita.
Jättämällä arvostelun annat Suomalaiselle Kirjakaupalle oikeuden käyttää kyseisiä arvosteluja omassa markkinoinnissaan (sekä painettu että digitaalinen) ilman erillistä korvausta. Arvosteluja käytetään myös analysointiin ja markkinoinnin kehittämiseen.
Tuotearvostelun jättäneiden kesken arvotaan säännöllisin väliajoin tuotepalkintoja. Tutustu arvonnan sääntöihin täällä.
Mikäli haluat poistaa jättämäsi tuotearvostelun verkkokaupastamme, pyyntö tästä tulee ohjata asiakaspalveluumme: asiakaspalvelu@suomalainen.com.
Tuotearvostelut eivät ole tarkoitettu asiakasreklamaatioiden tai tilauskyselyjen tekemiseen. Reklamaatiotapauksissa pyydämme ottamaan yhteyttä asiakaspalveluumme: asiakaspalvelu@suomalainen.com.
Jättämällä arvostelun suomalainen.com -verkkokauppaan hyväksyt yllämainitut käytännöt ja ehdot.
Lue lisää tuotearvosteluista.